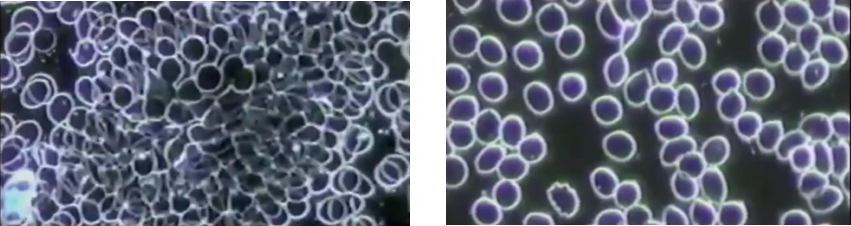
Cellular cleanse - Exposed to chemical or something

There have been many arguments about the alkalinity of the body and the relationship to cancer. I had to dig into this topic and know for myself! 1,2
Keeping a balance between acid forming and alkaline forming foods is often discussed in the context of cancer. Comments such as “I avoid acidic foods because cancer thrives in an acidic environment.” or “I have litmus strips to check my saliva (or urine) because somebody told me to monitor my body’s acidity.”
In the early 1900s, the Nobel-prize winning Dr. Otto Warburg, discovered that cancer cells were low in oxygen due to a change in cellular respiration from using oxygen to using fermentation of sugar. Summarized in a few words, the prime cause of cancer is the replacement of the respiration of oxygen in normal body cells by a fermentation of sugar.” These were revolutionary findings!
However, given these findings, it is easy to see where the acid-alkaline idea came from, BUT one must remember that science has dramatically advanced since these times.
Today’s Science: (this gets a bit deep)
In order for a cancer cell to grow, it relies on growth of blood vessels in efforts to provide enough oxygen to metabolize energy.3,4 However, the pace of cancer cell growth and division is quicker than the production of oxygen-supplying blood vessels.5 This results in the inefficient metabolism of its energy supply, and ultimately, lactic acid is produced.
Because the cancer cell is producing lactic acid, does not mean that the whole body becomes acidic.5 In fact, the body has a very tight set of checks and balances which keeps your blood’s (i.e., body’s) pH between 7.35 – 7.45, or near neutral. It is also impossible to significantly alter one’s blood pH with the food you eat. Therefore, checking your saliva for acidity or alkalinity is not an accurate measure of your body’s actual pH balance.
So, as you can see, it is not the body that is too acidic and gives cancer cells a medium to grow and divide. Rather, it’s the opposite. Cancer cells produce acid, but that does not make the entire body more acidic.
What can we do?
Fortunately, the same foods found to be alkaline as far back as the 1800s are many of the same foods that are recommended today for their cancer-fighting properties. These plant-based foods – including citrus fruits and tomatoes – protect cells from damage, encourage normal cell growth, and other processes which help fight cancer and other chronic illnesses.[5] Conversely, high-intakes acidic foods such as meat and animal-based proteins, have been linked to inflammation, insulin insensitivity, and increased cell division.
As you can see, the myth of the need to make the body more alkaline does not have significant value with respect to cancer cell growth or development. However, we do know that incorporating more alkaline-type foods is recommended. The American Institute for Cancer Research recommends a plant-based diet which aims at receiving at least five servings of fruits and vegetables per day (at least 2 ½ cups), using whole grains versus refined grains, incorporating beans/legumes more often and meat less often. Incorporating these dietary habits will limit your intake of acidic foods, increase your intake of alkaline foods, and provide your body with the cancer-fighting nutrients it craves.
Because the ISAGENIX IsaLean® shakes are formulated to have a neutral pH I feel great about continuing to incorporate them in my daily life. They are made with the best quality products and are nutrient rich and contain superior un-denatured whey and milk proteins. (A dairy-free version exists) They are more than a shake, it’s a meal replacement (240 cal.) with its proteins (24 g), energy-fueling carbohydrates (8 g fiber), good fats, and 23 vitamins and minerals per serving. It is used to replace conventional meals with 2 Shakes per day plus one healthy low-glycemic, 400-600 calorie meal as well as 2 snacks (More calories can be consumed once in weight maintenance).
1By Dianne Piepenburg, MS, RD, CSO, LD – Minnesota Oncology (mnoncology.com)
2What Otto Warburg Actually Discovered about Cancer (thetruthaboutcancer.com)
3Schor, Jacob. Acid Alkaline Diets and Cancer, an ethical question. December 12, 2007
4Nobel Peace Prize Winner Dr. Otto Heinrich Warburg: The Cause of Cancer
(https://michael2108.wordpress.com/2010/04/03/nobel-peace-prize-winner-dr-otto-heinrich-warburg-the-cause-of-cancer/)
5American Institute for Cancer Research (www.aicr.org)
These statements have not been evaluated by the Food and Drug Administration. The ISAGENIX products are not intended to diagnose, treat, cure, or prevent any disease.